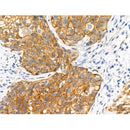
Phospho-alpha 1 Catenin (Ser655/Thr658) Antibody -AF3820

Description
Delivery Information
Payment & Security
Your payment information is processed securely. We do not store credit card details nor have access to your credit card information.

Your payment information is processed securely. We do not store credit card details nor have access to your credit card information.